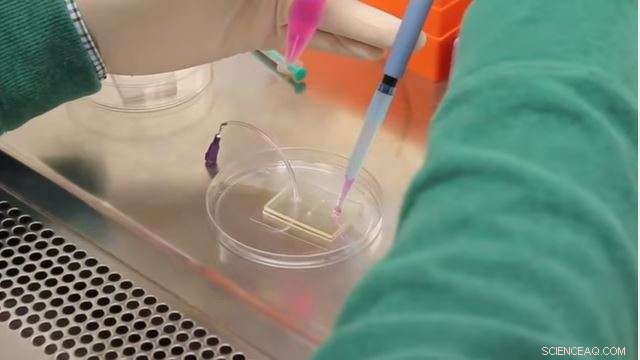
Engineered Blood Vessel Model Paves Way for Advanced Precision Medicine

A graphical schematic (left) and photograph (center) of the bi-layer device showing the upper (marked with yellow lines) and lower (marked with red lines) channel separated by a semi-permeable membrane. The schematic on the right depicts the culture of a monolayer of endothelial cell on the semi-permeable membrane and the manner in which TNF-α treatment is performed from the lower channel. B, (i) Bright field image of the upper (marked with yellow lines) and lower (marked with red lines) channel defining the upstream, TNF-α activated and downstream sections, (ii) Fluorescently labeled F-actin cytoskeleton (FITC phalloidin) images of confluent BAOEC layer aligned to flow (12 dyne/cm2 FSS for 24 hrs). The cells are cultured on the semi-permeable membrane in the upper channel of the device. Arrow shows flow direction (Scale bar: 100 μm) Credit: Yaling Liu
Nanotechnology has led to better diagnostic techniques and more effective treatments for a variety of illnesses. Tiny devices measuring between 1 and 100 micrometers—one micrometer is equal to one millionth of a meter—enable scientists to observe cell activity and deliver drugs to individual cells—a breakthrough that is on the verge of revolutionizing precision medicine for treatment of diseases such as cancer.
One obstacle to fulfilling nanomedicine's promise is the inability to observe cell to cell interactions at the nanoscale in an environment that closely simulates the dynamic environment inside the body. A micro-fluid environment that mimics blood flow is key to learning how cells become damaged by disease conditions—and how they might recover in response to treatment.
Now a team of researchers at Lehigh University and the University of Pennsylvania has developed a technique to observe cell to cell interaction at the nanoscale under micro-fluid conditions. They have successfully applied the technique to the study of blood vessel inflammation, a condition that sets the stage for heart disease, the number one cause of death in the U.S. and globally. Their findings have been published in Biomicrofluidics.
"We have shown that our technique can be successfully applied to the study of inflammation and are working on a way to similarly observe and intervene in the repair of tumor cells," said Yaling Liu, Associate Professor of Mechanical Engineering and Mechanics, Bioengineering at Lehigh and a co-author on the study.
Current in vitro drug testing is costly, time-consuming and relatively poor at predicting drug performance in vivo. The PharmaFlux technology is a micro-device testing service for drug candidates in mimicked disease micro-environments. Credit: Yaling Liu
Mimicking the dynamic transfer process
Chronic, low-grade inflammation is strongly associated with dysfunctional endothelial cells, which form the inner lining of blood vessels. The appearance of intercellular adhesion molecule-1 (ICAM-1) on the surface of endothelial cells, critical in regulating cell to cell interaction as part of the body's immune system response, is a sure sign that inflammation and disease are present. Therefore, observing the activation of endothelial cells under disease conditions is essential to understanding how heart disease develops and how to stop it.
The best way to observe these changes is inside the body. However, it is very difficult to do this. Observing the disease in a static cell culture—by removing and growing cells in an artificial environment such as a Petri dish—is limited in its ability to accurately portray the dynamic interactions under blood flow conditions.
In addition to Liu, the team from Lehigh includes Linda Lowe-Krentz, Professor, Biological Sciences; H. Daniel Ou-Yang, Professor, Physics; and Ph.D. student Antony Thomas. They collaborated with Vladimir R. Muzykantov, Professor of Pharmacology at Penn to develop a blood vessel on a chip in order to study the dynamics of ICAM-1 on the surface of endothelial cells activated under disease conditions.
"We were able to mimic and observe the dynamic transfer process—that moment when the intercellular adhesion molecule-1 antibody-coated nanoparticles binds to the cell signaling inflammation upregulation by endothelial cells—on a chip. We were also able to precisely control the flow of fluid," said Liu. "This reliable and relatively simple method simulates the conditions under which endothelial cells exist in the body, making it possible to observe cellular pathology in real time, and analyze differences in cells' responses to treatment."
An ideal drug-testing environment
Because this new technology creates a platform to focus on a particular diseased region, Liu and his colleagues believe it is ideally suited to testing new disease treatments.
Healthy cells exist on the very same chip as diseased cells, which allows for more localized control to test a particular drug. This, combined with the simulated blood flow environment, also allows researchers to gather a much more robust data set than they could by using a static culture.
The team's use of antibody-coated nanoparticles as imaging probes to assess the characteristics of cells is another key benefit of the new technology. Using the nanoparticle probes eliminates the need to employ radioisotope-labeled ICAM-1 antibodies to track cellular interactions— a technique that is fraught with regulatory and safety challenges. It is also very expensive.
"Our system provides a safer, less cost-prohibitive way to test a new drug in a setting that closely approximates a diseased region's environment," said Liu.
A "bridge" to precision medicine
The team's innovative platform also provides a crucial early look into a new drug's effectiveness and safety—a particularly important step considering the risks and expense associated with human clinical trials.
A 2012 study submitted to the U.S. Department of Health and Human Services detailed the costs of clinical drug trials. The authors of "Examination of Clinical Trial Costs and Barriers for Drug Development" estimated that the cost of completing clinical trials for a new drug is between approximately $50 million and $115 million depending on the therapeutic area—respiratory system and oncology being among the most expensive.
The study also identified clinical trial costs as a possible reason behind a slowdown in applications for new drug approvals. Between 2003 and 2012, the number of FDA approvals of new drugs per year fell from the previous decade's average of 30 to 25.7. The average yearly number of filings has also fallen slightly over the same time period. The authors state: "A reduction in the drug application pipeline means fewer novel therapies in future years."
The technology developed by the Lehigh and UPenn team offers pharmaceutical companies the ability to get an early look at the efficacy and safety profile of a new treatment before committing to clinical trials, thus incurring less risk and lower costs. According to Liu, this early look could act as a "bridge" between the development of a drug and human trials. Ultimately—and most importantly—providing this "bridge" could result in the development of more novel disease treatments that reach consumers more quickly.
By directly culturing patient cells in their biomimetic chip and testing under similar conditions observed in vivo, it may provide insights for precision medicine that is tailored to a specific patient under a patient specific environment.
Liu, along with with industry mentor Ira Weisberg (CEO of Amherst Pharmaceuticals) and entrepreneur lead Christopher Uhl (Bioengineering Ph.D. student at Lehigh) have received an NSF Innovation Corp grant and have been working with Lehigh University's Office of Technology Transfer to commercialize the technology under the company name PharmaFlux.
"As we continue to develop the platform beyond the study of inflammation," Liu says, "we hope to make a significant contribution to the acceleration of targeted drug delivery and help usher in a new age of better medicine."